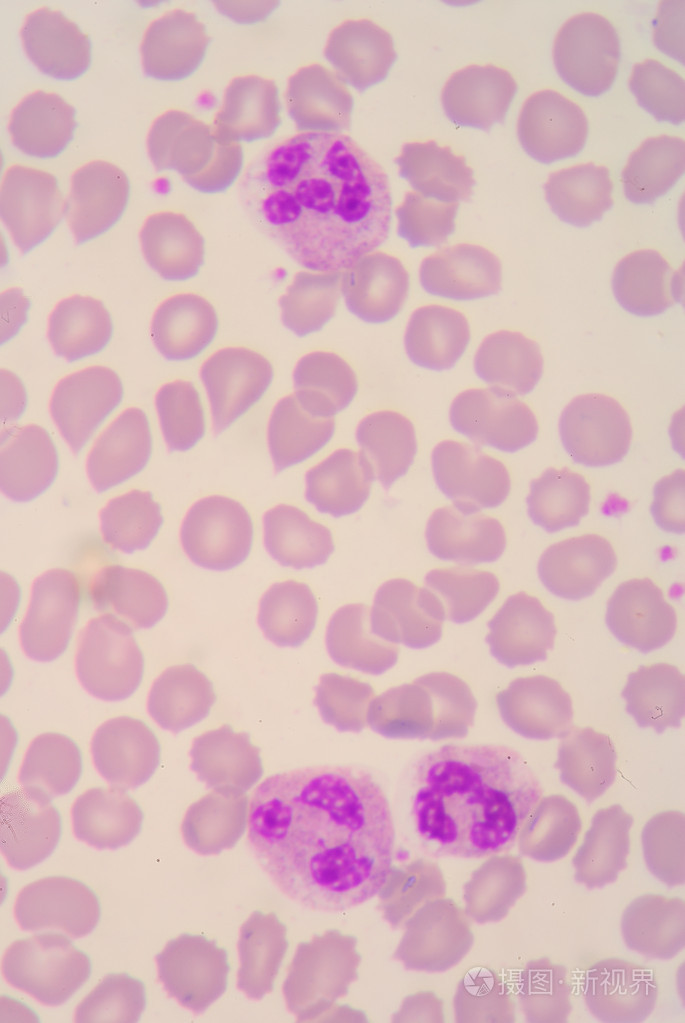
中性粒细胞
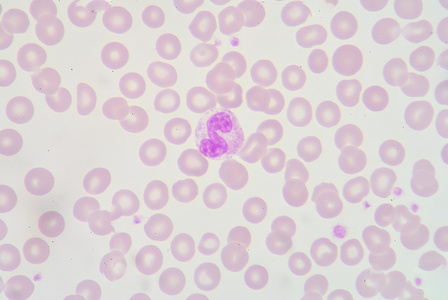
中性粒细胞照片
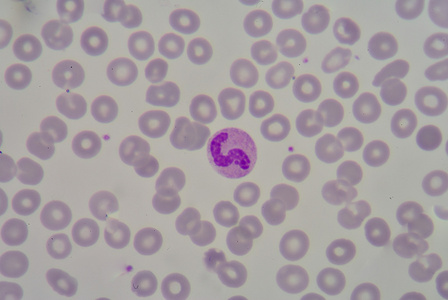
中性粒细胞照片

中性粒细胞形态
中性粒细胞胞
图片尺寸1200x900
中性粒细胞
图片尺寸685x1023中性粒细胞胞
图片尺寸900x1200
中性粒细胞
图片尺寸1500x1500
中性中幼粒细胞
图片尺寸545x480
中性中幼粒细胞 04
图片尺寸650x484
hypersegmented 中性粒细胞.
图片尺寸352x300
中性分叶核粒细胞 07
图片尺寸650x484
上面三张照片所选的观察部位并不适合进行白细胞形态学的观察,这里红
图片尺寸800x612
儿童中性粒细胞百分比偏低是什么原因导致的
图片尺寸941x941中性粒细胞胞
图片尺寸1200x800中性粒细胞胞
图片尺寸1200x900
中性中幼粒
图片尺寸464x810
中性杆状核粒细胞 06
图片尺寸650x484
中性粒细胞分比
图片尺寸800x534〈特点:形状不规则〉淋巴细胞〈特点:核大〉嗜酸性分叶核粒细胞中性
图片尺寸1080x1087
白细胞 红细胞 人的血细胞彩图 血小板
图片尺寸1080x810
中性粒细胞照片
图片尺寸448x300中性粒细胞胞
图片尺寸1200x900
中性粒细胞照片
图片尺寸448x300
猜你喜欢:中幼粒细胞中性粒细胞嗜酸性粒细胞形态晚幼粒细胞中性粒细胞淋巴细胞中性粒细胞工作细胞中性粒细胞特点中性粒细胞吞噬细菌中性粒细胞高中性粒细胞偏低中性粒细胞吞噬中性粒细胞图片中性粒细胞绘图中性粒细胞手绘中性粒细胞结构图中性粒细胞百分比偏低中性粒细胞百分比偏高中性粒细胞镜下图片中性粒细胞绝对值偏低中性粒细胞绘图红蓝中性粒细胞手绘图中性粒细胞红蓝铅笔中性粒细胞图片手绘中性粒细胞吞噬手绘图中性粒细胞红蓝铅笔图蝴蝶形态6种形态形态k线形态水的形态赛罗无限形态九爪螺图片英语飞行棋怎么画图片蜡笔小新合照图片纪梵希302芭比粉范无救谢必安漫画4k超清动态壁纸软件周瑛锋最早狗皮膏药 现代myholidayplan作文胡伟平云南挖耳草图片娜扎和热巴对比照片